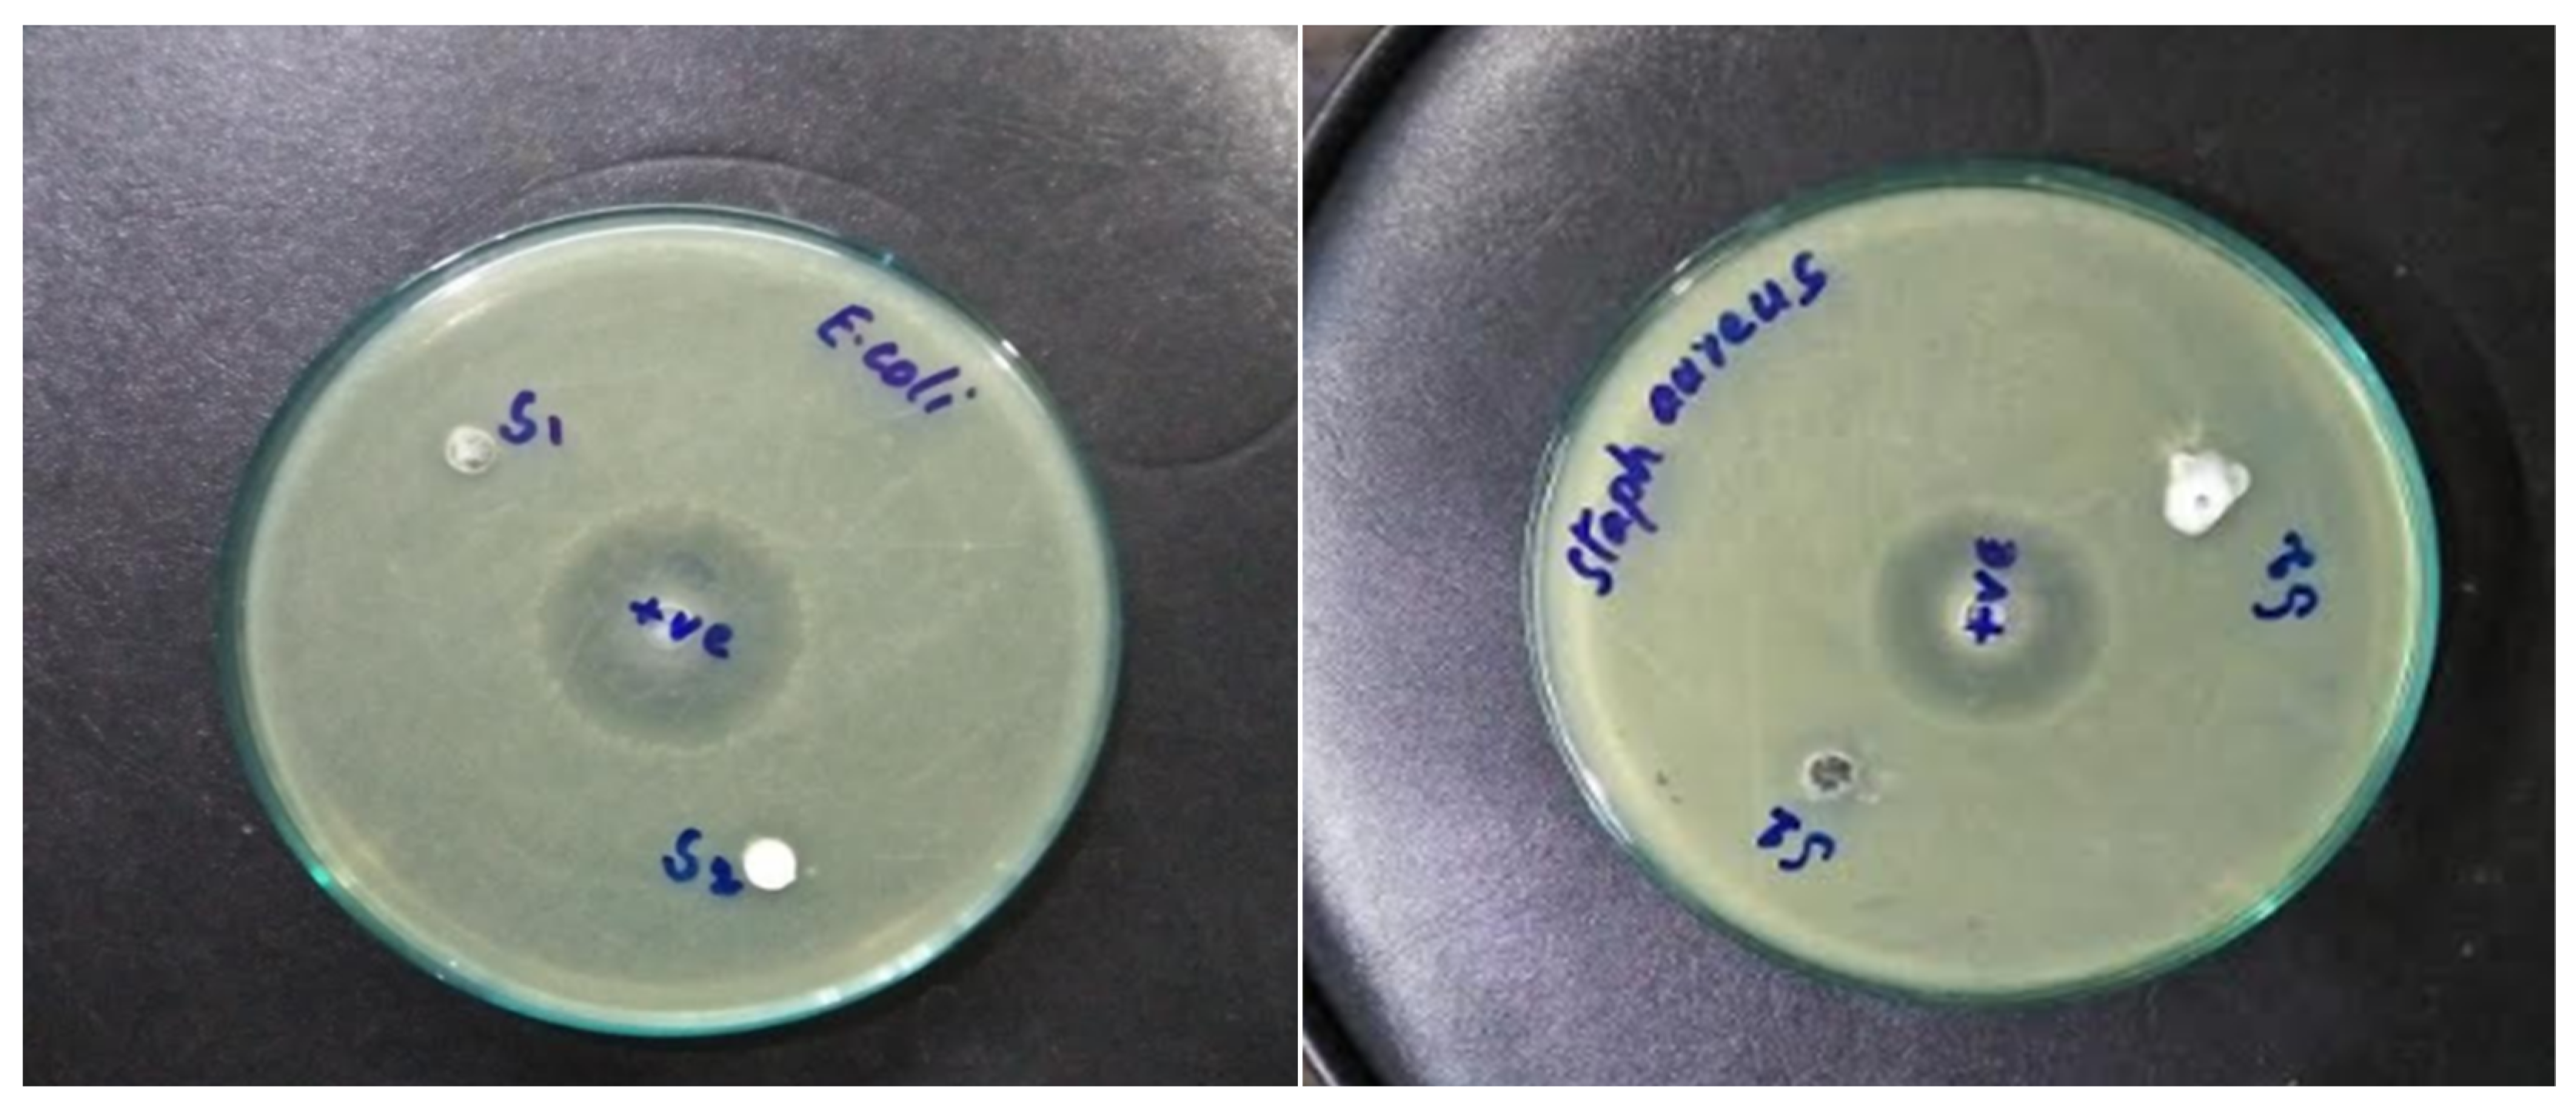
Nanomaterials 12 02122 g009

Evaluation of Ultrasonically ZnO Loading Effect on Photocatalytic Self-Cleaning, UV Protection and Antibacterial Activity of Plasma/Citric Acid-Activated Cotton Fabric
Abstract
:1. Introduction
2. Materials and Methods
2.1. Precursor Materials
2.2. Desizing of Cotton Samples
2.3. Preparation of Neem Extract
2.4. Activation of Cotton with DBD Plasma and Citric Acid
2.5. Synthesis and Coating of ZnO Nanoparticles on Activated Fabric
2.6. Antibacterial and Self-Cleaning Activities of ZnO-Coated Samples
2.7. Ultraviolet Protection
3. Results and Discussion
3.1. FTIR Analysis of DBD Plasma Treated Cotton
3.2. UV-Vis Analysis of ZnO Nanoparticles
3.3. XRD Analysis of ZnO-Coated Cotton
3.4. SEM Analysis of ZnO-Coated Cotton
3.5. Photocatalytic Activity
3.6. Coating Stability Test
3.7. Antibacterial Properties
3.8. Ultraviolet Protection Factor
4. Conclusions
Author Contributions
Funding
Institutional Review Board Statement
Informed Consent Statement
Data Availability Statement
Acknowledgments
Conflicts of Interest
References
- Saha, J.; Begum, A.; Mukherjee, A.; Kumar, S. A novel green synthesis of silver nanoparticles and their catalytic action in reduction of Methylene Blue dye. Sustain. Environ. Res. 2017, 27, 245–250. [Google Scholar] [CrossRef]
- Anwar, M.; Shukrullah, S.; Haq, I.U.; Saleem, M.; AbdEl-Salam, N.M.; Ibrahim, K.A.; Mohamed, H.F.; Khan, Y. Ultrasonic Bioconversion of Silver Ions into Nanoparticles with Azadirachta indica Extract and Coating over Plasma-Functionalized Cotton Fabric. ChemistrySelect 2021, 6, 1920–1928. [Google Scholar] [CrossRef]
- Saleem, M.; Naz, M.Y.; Shoukat, B.; Shukrullah, S.; Hussain, Z. Functionality and applications of non-thermal plasma activated textiles: A review. Mater. Today Proc. 2021, 47, S74–S82. [Google Scholar] [CrossRef]
- Berradi, M.; Hsissou, R.; Khudhair, M.; Assouag, M.; Cherkaoui, O.; El Bachiri, A.; El Harfi, A. Textile finishing dyes and their impact on aquatic environs. Heliyon 2019, 5, e02711. [Google Scholar] [CrossRef]
- Lellis, B.; Fávaro-Polonio, C.Z.; Pamphile, J.A.; Polonio, J.C. Effects of textile dyes on health and the environment and bioremediation potential of living organisms. Biotechnol. Res. Innov. 2019, 3, 275–290. [Google Scholar] [CrossRef]
- Amaro-Ortiz, A.; Yan, B.; D’Orazio, J.A. Ultraviolet radiation, aging and the skin: Prevention of damage by topical cAMP manipulation. Molecules 2014, 19, 6202–6219. [Google Scholar] [CrossRef] [PubMed]
- Tsuzuki, T.; Wang, X. Nanoparticle Coatings for UV Protective Textiles. Res. J. Text. Appar. 2010, 14, 9–20. [Google Scholar] [CrossRef]
- Bernhard, A.; Caven, B.; Wright, T.; Burtscher, E.; Bechtold, T. Improving the ultraviolet protection factor of textiles through mechanical surface modification using calendering. Text. Res. J. 2021, 92, 00405175211046624. [Google Scholar] [CrossRef]
- Arshad, H.M.U.; Anwar, H.; Javed, Y.; Naz, M.Y.; Ghaffar, A.; Khan, M.Z.; Farooq, Z. Investigation of photo-catalytic degradation of methylene orange dye using titanium dioxide–zinc oxide nanocomposites. Mater. Res. Express 2019, 6, 125009. [Google Scholar] [CrossRef]
- Irfan, M.; Naz, M.Y.; Saleem, M.; Tanawush, M.; Głowacz, A.; Glowacz, W.; Rahman, S.; Mahnashi, M.H.; Alqahtani, Y.S.; Alyami, B.A.; et al. Statistical Study of Nonthermal Plasma-Assisted ZnO Coating of Cotton Fabric through Ultrasonic-Assisted Green Synthesis for Improved Self-Cleaning and Antimicrobial Properties. Materials 2021, 14, 6998. [Google Scholar] [CrossRef]
- Sankar, R.; Rizwana, K.; Shivashangari, K.S.; Ravikumar, V. Ultra-rapid photocatalytic activity of Azadirachta indica engineered colloidal titanium dioxide nanoparticles. Appl. Nanosci. 2015, 5, 731–736. [Google Scholar] [CrossRef] [Green Version]
- Rajendaran, K.; Muthuramalangam, R.; Ayyadurai, S. Azadirachta indica as a bio-material: Rapid synthesis of Cr5O12 shell nanoparticles to study its photocatalytic and antimicrobial properties. J. King Saud Univ.-Sci. 2019, 31, 1235–1244. [Google Scholar] [CrossRef]
- He, X.; Yang, D.-P.; Zhang, X.; Liu, M.; Kang, Z.; Lin, C.; Jia, N.; Luque, R. Waste eggshell membrane-templated CuO-ZnO nanocomposites with enhanced adsorption, catalysis and antibacterial properties for water purification. Chem. Eng. J. 2019, 369, 621–633. [Google Scholar] [CrossRef]
- Zhang, X.; Sun, G.; Jia, S.; Xie, H.; Kang, Z.; Chen, W.; Cui, M.; Wang, B.; Wang, B.; Chen, X.; et al. Intrinsic carbon defects induced nickel phosphate/carbon photocatalyst for high performance bacterial disinfection. Chem. Eng. J. 2022, 438, 135624. [Google Scholar] [CrossRef]
- Ahmad, I.; Akhtar, M.S.; Ahmed, E.; Ahmad, M.; Naz, M.Y. Lu modified ZnO/CNTs composite: A promising photocatalyst for hydrogen evolution under visible light illumination. J. Colloid Interface Sci. 2021, 584, 182–192. [Google Scholar] [CrossRef] [PubMed]
- Ahmad, I.; Shukrullah, S.; Naz, M.Y.; Ahmad, M.; Ahmed, E.; Akhtar, M.S.; Rehman, S.U.; Makhlouf, M.M. Efficient hydrogen evolution by liquid phase plasma irradiation over Sn doped ZnO/CNTs photocatalyst. Int. J. Hydrog. Energy 2021, 46, 30019–30030. [Google Scholar] [CrossRef]
- Nourbakhsh, S.; Montazer, M.; Khandaghabadi, Z. Zinc oxide nano particles coating on polyester fabric functionalized through alkali treatment. J. Ind. Text. 2018, 47, 1006–1023. [Google Scholar] [CrossRef]
- Saleem, M.; Naz, M.Y.; Shukrullah, S.; Ali, S.; Hamdani, S.T.A. Ultrasonic biosynthesis of TiO2 nanoparticles for improved self-cleaning and wettability coating of DBD plasma pre-treated cotton fabric. Appl. Phys. A 2021, 127, 608. [Google Scholar] [CrossRef]
- Ali, A.; Baheti, V.; Vik, M.; Militky, J. Copper electroless plating of cotton fabrics after surface activation with deposition of silver and copper nanoparticles. J. Phys. Chem. Solids 2020, 137, 109181. [Google Scholar] [CrossRef]
- Zambri, N.D.S.; Taib, N.I.; Abdul Latif, F.; Mohamed, Z. Utilization of Neem Leaf Extract on Biosynthesis of Iron Oxide Nanoparticles. Molecules 2019, 24, 3803. [Google Scholar] [CrossRef] [Green Version]
- Louris, E.; Sfiroera, E.; Priniotakis, G.; Makris, R.; Siemos, H.; Efthymiou, C.; Assimakopoulos, M.N. Evaluating the ultraviolet protection factor (UPF) of various knit fabric structures. IOP Conf. Ser. Mater. Sci. Eng. 2018, 459, 012051. [Google Scholar] [CrossRef]
- Mahalakshmi, S.; Hema, N.; Vijaya, P.P. In Vitro Biocompatibility and Antimicrobial activities of Zinc Oxide Nanoparticles (ZnO NPs) Prepared by Chemical and Green Synthetic Route—A Comparative Study. BioNanoScience 2020, 10, 112–121. [Google Scholar] [CrossRef]
- Musa, I.; Qamhieh, N.; Mahmoud, S.T. Synthesis and length dependent photoluminescence property of zinc oxide nanorods. Results Phys. 2017, 7, 3552–3556. [Google Scholar] [CrossRef]
- Almessiere, M.; Slimani, Y.; Korkmaz, A.D.; Guner, S.; Sertkol, M.; Shirsath, S.E.; Baykal, A.J.U.S. Structural, optical and magnetic properties of Tm3+ substituted cobalt spinel ferrites synthesized via sonochemical approach. Ultrason. Sonochem. 2019, 54, 1–10. [Google Scholar] [CrossRef]
- Verma, A.; Mehata, M.S. Controllable synthesis of silver nanoparticles using Neem leaves and their antimicrobial activity. J. Radiat. Res. Appl. Sci. 2016, 9, 109–115. [Google Scholar] [CrossRef] [Green Version]
- Muhammad, W.; Ullah, N.; Haroon, M.; Abbasi, B.H. Optical, morphological and biological analysis of zinc oxide nanoparticles (ZnO NPs) using Papaver somniferum L. RSC Adv. 2019, 9, 29541–29548. [Google Scholar] [CrossRef] [Green Version]
- Vinisha Rani, K.; Sarma, B.; Sarma, A. Plasma treatment on cotton fabrics to enhance the adhesion of Reduced Graphene Oxide for electro-conductive properties. Diam. Relat. Mater. 2018, 84, 77–85. [Google Scholar] [CrossRef]
- Saravanan, R.; Gupta, V.K.; Narayanan, V.; Stephen, A. Comparative study on photocatalytic activity of ZnO prepared by different methods. J. Mol. Liq. 2013, 181, 133–141. [Google Scholar] [CrossRef]

| Sample | Electrical Resistivity (Ω-mm) | Fabric Weight (gsm) | ||
|---|---|---|---|---|
| Before Washing | After Washing | Before Washing | After Washing | |
| Control | 149 | 174 | 272.6 | 237.3 |
| P1 | 122 | 126 | 283.1 | 277.9 |
| P2 | 127 | 137 | 276.4 | 259.3 |
| Washing Cycles | E. coli | S. aureus | ||
|---|---|---|---|---|
| P1 | P2 | P1 | P2 | |
| 0 | 5.5 mm | 5.2 mm | 5.4 mm | 5.3 mm |
| 10 | 4.6 mm | 4.2 mm | 4.5 mm | 4.4 mm |
Publisher’s Note: MDPI stays neutral with regard to jurisdictional claims in published maps and institutional affiliations. |
© 2022 by the authors. Licensee MDPI, Basel, Switzerland. This article is an open access article distributed under the terms and conditions of the Creative Commons Attribution (CC BY) license (https://creativecommons.org/licenses/by/4.0/).
Share and Cite
Irfan, M.; Hussain, H.; Saleem, B.; Saleem, M.; Shukrullah, S.; Legutko, S.; Petrů, J.; Naz, M.Y.; Pagáč, M.; Rahman, S.; et al. Evaluation of Ultrasonically ZnO Loading Effect on Photocatalytic Self-Cleaning, UV Protection and Antibacterial Activity of Plasma/Citric Acid-Activated Cotton Fabric. Nanomaterials 2022, 12, 2122. https://doi.org/10.3390/nano12122122
Irfan M, Hussain H, Saleem B, Saleem M, Shukrullah S, Legutko S, Petrů J, Naz MY, Pagáč M, Rahman S, et al. Evaluation of Ultrasonically ZnO Loading Effect on Photocatalytic Self-Cleaning, UV Protection and Antibacterial Activity of Plasma/Citric Acid-Activated Cotton Fabric. Nanomaterials. 2022; 12(12):2122. https://doi.org/10.3390/nano12122122
Chicago/Turabian StyleIrfan, Muhammad, Humaira Hussain, Bisma Saleem, Muhammad Saleem, Shazia Shukrullah, Stanislaw Legutko, Jana Petrů, Muhammad Yasin Naz, Marek Pagáč, Saifur Rahman, and et al. 2022. "Evaluation of Ultrasonically ZnO Loading Effect on Photocatalytic Self-Cleaning, UV Protection and Antibacterial Activity of Plasma/Citric Acid-Activated Cotton Fabric" Nanomaterials 12, no. 12: 2122. https://doi.org/10.3390/nano12122122
APA StyleIrfan, M., Hussain, H., Saleem, B., Saleem, M., Shukrullah, S., Legutko, S., Petrů, J., Naz, M. Y., Pagáč, M., Rahman, S., & Khan, R. (2022). Evaluation of Ultrasonically ZnO Loading Effect on Photocatalytic Self-Cleaning, UV Protection and Antibacterial Activity of Plasma/Citric Acid-Activated Cotton Fabric. Nanomaterials, 12(12), 2122. https://doi.org/10.3390/nano12122122









